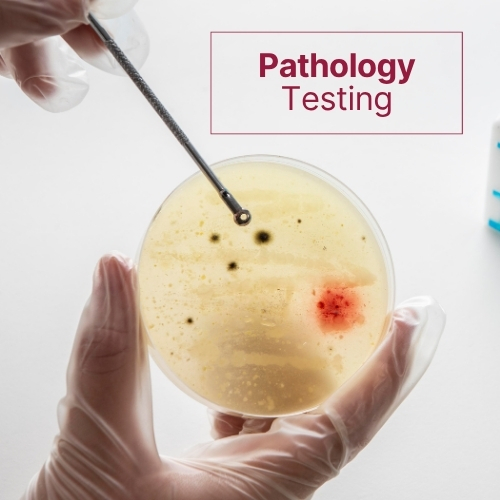

Welcome To The Top Cancer Centre in Ahmedabad
As a leading cancer hospital in Ahmedabad, we at HOC Vedanta believe that every patient deserves more than just treatment – they deserve understanding, expertise, and compassionate care at each page of their healing journey.
Founded with a singular vision to make quality care for cancer and blood disorder accessible, HOC Vedanta is the only comprehensive clinic dedicated exclusively to the diagnosis and treatment of cancers and hematological diseases, making it the best cancer hospital in Gujarat.
Our clinic is backed by a robust diagnostic laboratory and a cutting-edge clinical research facility – ensuring that our approach is not only thorough, but also at the forefront of medical advancement. From early diagnosis to long-term management, we have earned the trust of our patients by covering every aspect of your care with precision and empathy, unlike any other cancer hospital in Ahmedabad.

With five well-established chemotherapy centres located at Navrangpura, Rajpath, Maninagar, Nikol & Bopal, our presence across Ahmedabad ensures that expert care is always within reach. Each one of HOC Vedanta’s cancer hospitals in Ahmedabad is equipped to provide safe, streamlined treatment in a supportive environment - because where you heal matters.
Whether you’re seeking a diagnosis, long-term care, or a second opinion, our team of experienced oncologists, hematologists, and support staff are here to guide you with honesty, clarity, and unwavering support.
Welcome to a state-of-the-art cancer hospital in Ahmedabad, HOC Vedanta - where care is personal, science is trusted, and your fight is ours to share.
Latest Update
As coronavirus continues to spread across the country, it's critical that everybody takes precautions to keep themselves & others safe.
Our all branch Navrangpura, Rajpath, Maninagar & Nikol have started functional with most precaution activities such as
- Thermal screening and sanitizing area before premise’s entry, Patient and relative’s screening by medical officer before OPD/IPD entry
- One Patient One Relative, Social Distancing at Reception Waiting Area.
- Chemotherapy drug preparation with proper safety measures,
- Safety gears for frontline staff, Daily fumigation and sanitization of patient’s ward, waiting area, outside premises and consulting rooms,
- Special Triage area for immune-compromised patients.
We request you to stay indoor & not to visit for any Routine check up, if not necessary.
We will available on call for any emergencies
+91 90990 07705 /+91 98245 14477.
You can also avail Tele-Consultation for our New & Follow-up Patient. Rajpath (9099807706), Navrangpura (9099007706), Maninagar (9327741385) & Nikol (8128347706) (WhatsApp us & Our Team will get back to you asap)
We have also started Home Visit for Blood Collection as well as Home Care, For more details, please do call on below number Home Visit Blood Collection : Navrangpura (9601386037), Rajpath (9099307706), Maninagar (6352367862) Home Care - 8401147671
News & Events
APA in association with HOC invites you for Lung Cancer Symposium
Women Empowerment at HOC.
HAPPY INTERNATIONAL WOMEN'S DAY
World Cancer Awareness Day
HOC News
Anti Tobacco Day

Hematology & Oncology
It is the only clinic in Gujarat which provides comprehensive treatment of cancers.
Read More...
Chemotherapy
We have a 14 bedded centre on the ground floor of the hospital, run by a fully trained staff.
Read More...
Indoor Pathology Laboratory
The Vedanta Diagnostics Centre also serves as aservice laboratory to clinical.
Read More...
Clinical Research
The Clinical Research Centre at Vedanta provides resources for support of a wide array.
Read More...